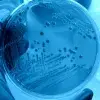

Con el objetivo de implementar soluciones innovadoras a problemas urbanos, alumnos del Tec de Monterrey campus Sonora Norte participaron en el concurso Multi-City Challenge y obtuvieron el primer lugar con sus propuestas para el municipio de Hermosillo.
El reto Multi-City Challenge forma parte del programa City Challenges de The GovLab de la Universidad de Nueva York.
El primer premio se obtuvo en la categoría de Movilidad Sostenible por las alumnas y el alumno: Luisa María Verdugo Rodríguez, Marianna Longoria Granados y Omar Garza Ortega, estudiantes de la Escuela de Arquitectura, Arte y Diseño (EAAD).
También en la categoría Reactivación Económica donde la alumna Ximena Romo Soto resultó acreedora al primer puesto.

La invitación a la EAAD del Tec de Monterrey, surgió por parte de la directora del Instituto Municipal de Planeación en Hermosillo (IMPLAN), Arq. Guadalupe Peñuñuri.
“Los alumnos de la EAAD de Sonora Norte tienen constante participación en proyectos de beneficio para el municipio y siempre con muy buenos resultados” mencionó la directora de la EAAD, Diana Urías.
Las propuestas ganadoras en el Multi-City Challenge
Durante la premiación estuvo presente de manera virtual, la alcaldesa de Hermosillo, Celida López quién felicitó a los participantes de ambas categorías.
“Nuestros retos como capital de Sonora es resolver una movilidad sostenible, una reactivación económica basada en una economía circular” mencionó Celida López.
“Esta es una ciudad que tiene una deuda de más espacios públicos para la convivencia y de la naturaleza” agregó Celida López.
Las propuesta ganadora en la categoría de Movilidad Sostenible fue “Urbanismo táctico y estaciones de eco bici” por los alumnos Luisa, María y Omar del campus Sonora Norte, con apoyo de la profesora Marcela Orozco y el profesor Rogelio Cota.
“Es una estrategia de movilidad urbana mediante la implementación de urbanismo táctico en la colonia Cinco de Mayo en la ciudad de Hermosillo” explicó Omar sobre el proyecto.
“El objetivo es promover y facilitar los desplazamientos de peatón y ciclista mediante señalización y orejas peatonales, así como también ciclo carriles” continuó.
En la categoría reactivación económica, la propuesta “Mercado itinerante” por la alumna Ximena, asesorada por el profesor Francisco Ibarra.
La alumna manifestó que su propuesta es un mercado movible por la ciudad, esto a favor de los negocios que han tenido que cerrar sus puertas a causa de la pandemia por COVID-19.
“Esta idea nace de crear módulos con materiales reciclados y así las personas puedan presentar sus productos al público sin tener que pagar altas rentas y así también contribuir a una economía circular” concluyó.
Los proyectos ganadores recibirán asesoría por parte de la Universidad de Nueva York a través de The Gov Lab, Cirklo y equipos del gobierno municipal.
“El objetivo será desarrollar e implementar sus propuestas, una oportunidad única para nuestros estudiantes para llevar a la realidad estas ideas que impactan positivamente a nuestras comunidades” agregó Diana Urías.
La directora añadió que el proyecto se planteó como repentina de diseño para los alumnos por el corto tiempo para desarrollar propuestas apegadas a los Objetivos de Desarrollo Sostenible de Naciones Unidas.
“Esto nos impulsa a seguir participando en estos foros que brindan la oportunidad de generar un impacto real y tangible en nuestras comunidades, que finalmente es lo que buscamos: formar líderes y agentes de cambio positivo para nuestra sociedad” concluyó.